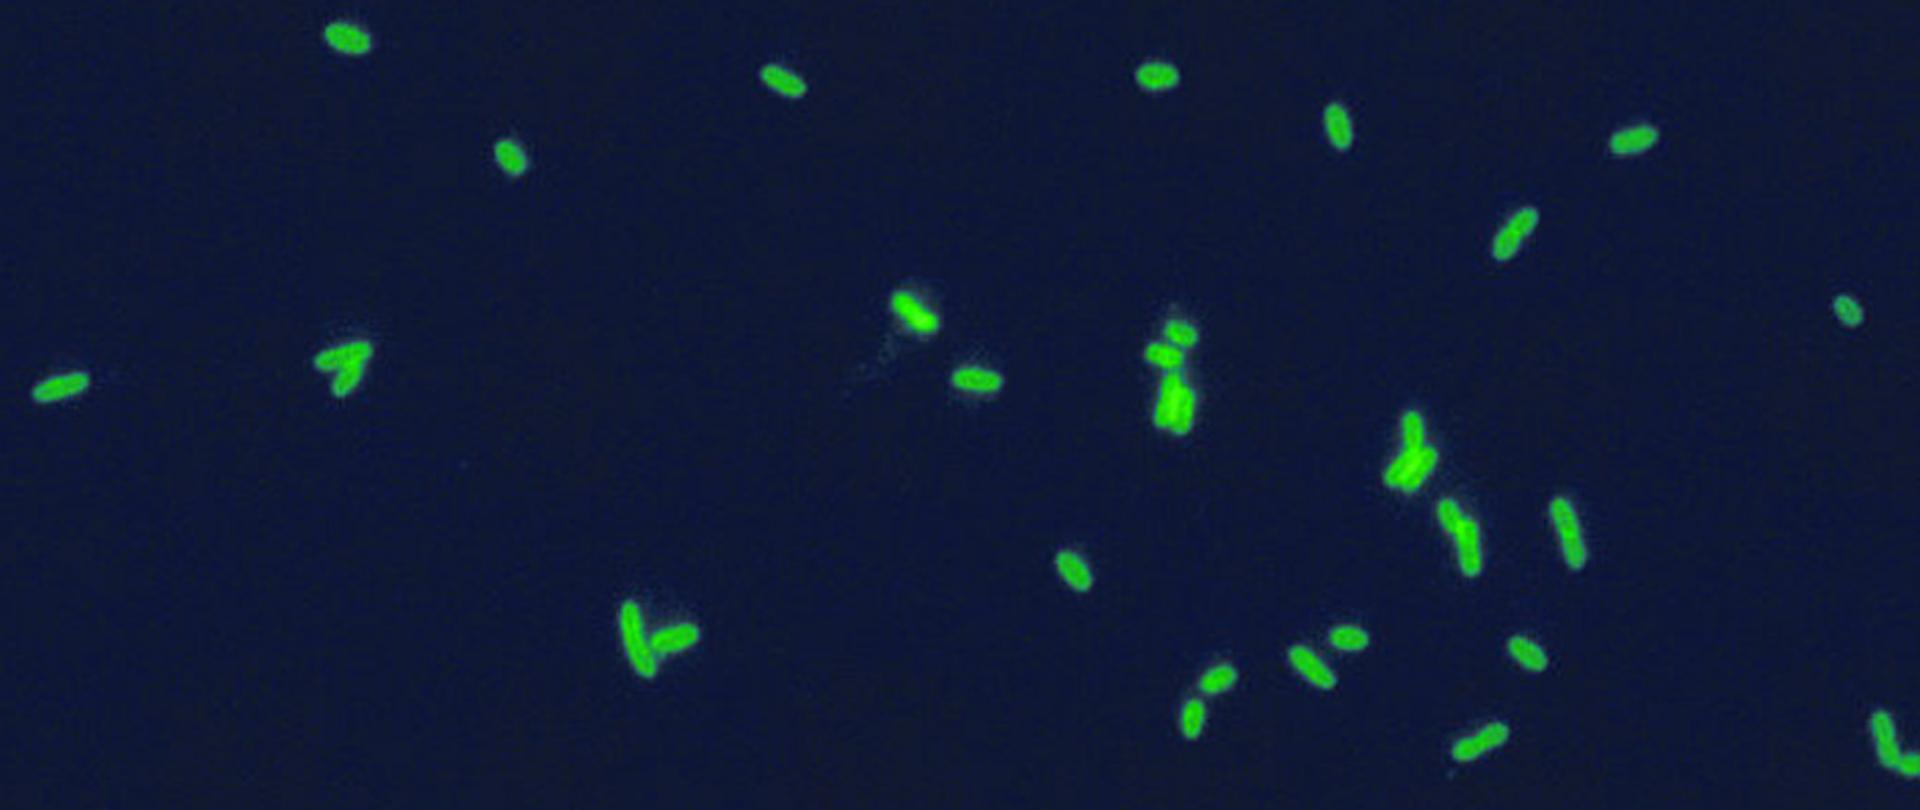
Legionella

Bakterie Legionella sp. w instalacjach wody ciepłej
21.06.2024
Co to jest bakteria Legionella sp.?
Bakteria Legionella sp. to bakteria występująca powszechnie w środowisku wodnym i obejmuje co najmniej 50 gatunków, z których 25 jest chorobotwórczych dla ludzi. Ww. bakterie nie tworzą form przetrwalnikowych, dlatego też te drobnoustroje są wrażliwe na dezynfekcję [1,2].
Źródła i drogi zakażenia
Najpowszechniejszą drogą zakażenia jest droga inhalacyjna. Do zakażenia może dojść poprzez aspirację w przypadku skażenia wody, żywności i lodu [2,3]. Ryzyko zakażenia tymi bakteriami związane jest przede wszystkim z użytkowaniem urządzeń i elementów wewnętrznego systemu wodociągowego, które wytwarzają aerozole wodne m.in.:
- systemy dystrybucji wody ciepłej i zimnej m.in. zbiorniki do magazynowania wody, podgrzewacze, głowice natryskowe,
- baseny z hydromasażem/typu SPA/whirlpool,
- fontanny,
- systemy klimatyzacyjne z nawilżaniem powietrza (np. komory zraszania, skraplacze wyparne),
- urządzenia i instalacje wód chłodniczych (wieże chłodnicze) [3,4,5].
Wpływ bakterii na zdrowie człowieka
Bakteria Legionella sp. jest odpowiedzialna za przypadki zachorowań na legionellozę, która występuje w dwóch postaciach klinicznych: choroby legionistów i gorączki Pontiac. Pierwsza z nich przebiega w sposób niespecyficzny, a ciężkość przebiegu może wahać się od lekkiego (kaszel, lekka gorączka) do bardzo ciężkiego z niewydolnością oddechową zagrażającego życiu chorego. Mogą również pojawić się objawy ze strony układu nerwowego np. zawroty głowy, splątanie oraz ze strony układu pokarmowego np. bóle brzucha, biegunki, nudności. Okres inkubacji wynosi od 3 do 10 dni. Gorączka Pontiac to choroba o łagodniejszym przebiegu. Charakteryzuje się objawami przypominającymi grypę: gorączka, ból głowy i mięśni. Okres inkubacji wynosi od 5 godz. do 3 dni, a wyleczenie następuje samoistnie po 3 do 5 dni. [2,3,5].
Czynniki środowiskowe sprzyjające występowaniu i namnażaniu bakterii Legionella sp.
Występowaniu i namnażaniu się omawianej bakterii sprzyja przede wszystkim [2,3,5,6]:
- temperatura w zakresie od 20ºC do 45ºC,
- obecność biofilmu, osadów, korozji,
- gromadzenie się glonów, mułu, pierwotniaków,
- elementy instalacji pokryte osadem wapiennym, kamieniem kotłowym: prysznice, wylewki baterii, nasadki sitkowe baterii umywalkowych,
- niewłaściwa konserwacja i brak ciągłości w używaniu wyposażenia i urządzeń w punktach czerpalnych,
- zastoiny wody w rurach,
- nieczynne lub rzadko używane odgałęzienia o bardzo małym przepływie wody,
- brak lub zbyt małe stężenie środków dezynfekcyjnych.
Działania profilaktyczne zapobiegające namnażaniu się bakterii Legionella sp. w instalacjach i urządzeniach wodnych [4,6]:
- w instalacjach wody ciepłej temperatura wody opuszczającej podgrzewacz powinna przekraczać 60ºC, natomiast w całej instalacji utrzymywać temperaturę wody powyżej 55ºC, podgrzewacz wody po dłuższym okresie nieużytkowania powinien być opróżniony z wody i poddany zabiegom czyszczenia,
- największej liczby punktów wypływu wody w poszczególnych obszarach np. na piętrach, pionach. Ma to na celu wymianę wody na świeżą oraz zapewnienie właściwej temperatury wody w punkcie czerpalnym (dla wody ciepłej co najmniej 55ºC, poniżej 25ºC dla zimnej) oraz utrzymanie na odpowiednim poziomie stężenia środka dezynfekcyjnego we wszystkich punktach,
- usuwanie w instalacjach tzw. ślepych odcinków oraz nieużytkowanych odcinków o niskim natężeniu przepływu w celu zminimalizowania ryzyka stagnacji wody,
- czyszczenie wodnych urządzeń o funkcji dekoracyjnej np. fontanny oraz zapewnienie przed ich uruchomieniem, aby elementy instalacji, tj. zbiorniki, ściany, niecki były wolne od biofilmu lub szlamu, w razie konieczności należy przeprowadzić ich dezynfekcję i czyszczenie,
- kontrola i czyszczenie basenów z hydromasażem/typu SPA/typu whirlpool oraz zapewnienie przed ich uruchomieniem, aby elementy instalacji, tj. zbiorniki, ściany, niecki były wolne od biofilmu lub osadu, w razie konieczności przeprowadzić ich dezynfekcję i czyszczenie,
- kontrola i czyszczenie systemów klimatyzacyjnych poprzez utrzymywanie odpowiedniego stanu technicznego wież chłodniczych, komór zraszania zgodnie z wytycznymi producenta i najlepszymi praktykami branżowymi, eksploatowanie zgodnie z instrukcją oraz prowadzenie systematycznej kontroli wizualnej elementów systemu, w celu potwierdzenia ich czystości i właściwego nadzorowania. Przed włączeniem do użytkowania, wieża i basen/zbiorniki ociekowe powinny być wolne od szlamu, gruzu i biofilmu (w razie konieczności wskazane jest przeprowadzenie czyszczenia), a przed ponownym uruchomieniem zaleca się zapobiegawczo przeprowadzić dezynfekcję,
- dokonywanie przeglądów stanu technicznego wewnętrznych systemów wodociągowych, ze szczególnym uwzględnieniem: doboru wielkości systemu do aktualnych potrzeb, szczelności przewodów, wzajemnej izolacji przewodów ciepłej i zimnej wody (ryzyko schładzania ciepłej wody i ogrzewania zimnej), stanu technicznego podgrzewacza wody, utrzymania odpowiedniej temperatury wody ciepłej, sprawdzania stężenia środków dezynfekcyjnych (w przypadku obiektów, w których stosowana jest dezynfekcja chemiczna),
- kontrolowanie temperatury wody wypływającej z podgrzewacza oraz w poszczególnych punktach jej wypływu z kranu (zarówno ciepłej, jak i zimnej wody) oraz prowadzenie dokumentacji dotyczącej okresowych przeglądów i kontroli temperatury,
- podniesienie świadomości osób zarządzającymi obiektami, poprzez udział w szkoleniach z zakresu zarządzania oraz oceny potencjalnego ryzyka związanego z wewnętrznymi systemami wodociągowymi i występowaniem w nich bakterii Legionella sp.,
- wykonywanie badań jakości wody ciepłej na obecność bakterii Legionella sp. zgodnie z częstotliwością określoną w załączniku nr 5 rozporządzenia Ministra Zdrowia z dnia 7 grudnia 2017 r. w sprawie jakości wody przeznaczonej do spożycia przez ludzi (Dz.U. z 2017 r. poz. 2294 ze zm.).
Literatura:
- A. Matejuk, U. Posmyk, K. Simon „Występowanie pałeczek Legioenlla sp. w instalacjach wodnych obiektów użyteczności publicznej w województwie opolskim w latach 2010-2011”, Przegląd Epidemiologiczny 2012, 66, 623-628.
- Wytyczne dotyczące jakości wody do picia. Wydanie czwarte, Izba Gospodarcza, Wodociągi Polskie. Tłumaczenie: A. Kruk, K. Miszta-Kruk.
- D. Maziarka, R. Matuszewska, B. Krogulska „Zagrożenia zdrowotne związane z występowaniem bakterii Legionella w instalacjach wodnych zakładów opieki zdrowotnej. Interpretacja wyników badań wody oraz przegląd zaleceń i przepisów w wybranych krajach., Warszawa 2016.
- Zalecenia dotyczące ponownego otwierania budynków użyteczności publicznej i zamieszkania zbiorowego po wydłużonym przestoju lub ograniczonej eksploatacji, w ramach działań zapobiegających zakażeniom bakteriami z rodzaju Legionella https://www.gov.pl/web/gis/zapobieganie-zakazeniom-bakteriami-z-rodzaju-legionella--zalecenia-dot-ponownego-otwierania-budynkow-uzytecznosci-publicznej-i-zamieszkania-zbiorowego-po-wydluzonym-przestoju-lub-ograniczonej-eksploatacji2.
- B. Krogulska, R. Matuszewska, D. Maziarka, A. Kroguslki, M. Szczotko, M. Bartosik „Zalecenia dotyczące ograniczenia występowania zanieczyszczeń mikrobiologicznych, w tym bakterii z rodzaju Legionella, w systemach wody technologicznej/chłodniczej i w sanitarnych instalacjach wody ciepłej w zakładach przemysłowych, Warszawa 2013.
- D. Cunliffe, J. Bartram, E. l Briand, Y. Chartier, J. Colbourne, D. Drury, J.Lee, B. Schaefer oraz S.Surman-Le, „Bezpieczeństwo wodne w budynkach”, Wydane przez Światową Organizację Zdrowia w 2011 r. pod tytułem: Water safety in buildings.
Materiały
Zapobieganie zakażeniom powodowanym przez bakterie Legionella - zalecenia dot. ponownego otwierania budynkówzapobieganie-zakazeniom-powodowanym-przez-bakterie-legionella-zalecenia-dot-ponownego-otwierania-budynkow.pdf 0.69MB